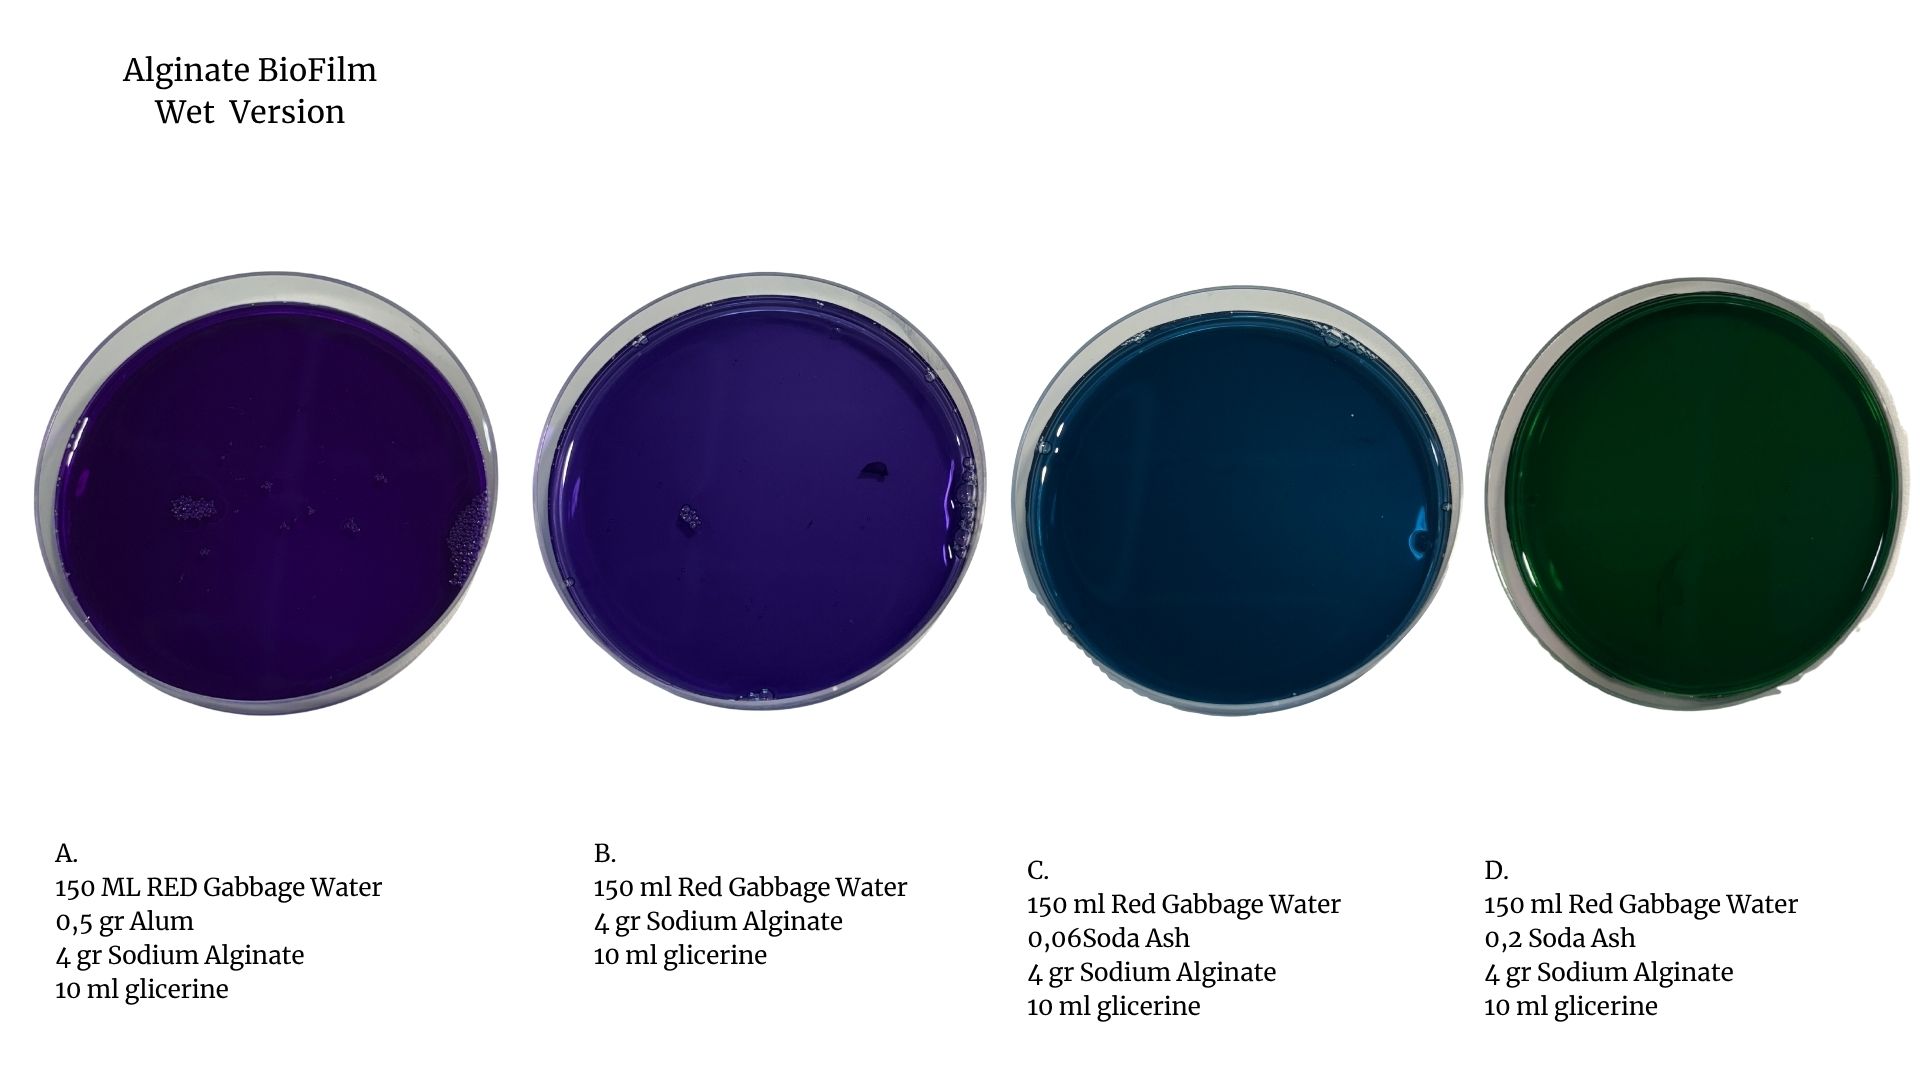

4. BioChromes¶
Research¶
Living Colors
- Natural Pigments Painting by Berrak Zeynep Okyar*
A collaborative works with Carlotta Premazzi with mentorship Carolina Delgado
Global class by Cecilia Raspanti
This week, we focused on learning both the theory and practice of natural pigments and biochromes. We learned that biochromes are natural colorants derived from plant or animal sources, and they are environmentally friendly, bio-based, and can be produced with zero waste. Natural dyes only work on natural fibers, so we studied the types of fibers such as cotton, linen, silk, and wool. We also learned that through a process called mordanting, these fibers can be made more receptive to natural dyes.
We explored the various natural sources of biochromes, including plants, fungi, soil, bacteria, and insects, which can be used to produce inks, dyes, and pigments.
In the practical part of our work, we used alginate, a natural biopolymer derived from algae. We prepared an alginate solution and used it to create a biofilm. We then applied a single natural pigment onto this biofilm to produce an alginate painting. Although we did not experiment with multiple pigments, this allowed us to observe how the alginate material interacts with the natural dye, and how it can be used in combination with bio-based coloring methods.
Through this process, we gained foundational knowledge of natural dyeing and had the opportunity to create our first sample using alginate-based material. We also developed a deeper understanding of the importance of working with natural and sustainable materials.
Assignment¶
A. Produce at least one natural dye or alginate (biofilm) based painting ink:
- Natural dye - Modify its color and use different mordanting methods to dye at least two different types of fibers (e.g., cotton, wool, silk, etc.).
B. Produce at least one botanical ink:
-
Botanical ink: Explore different materials and recipes. Learn how to adjust the recipe based on the ingredients used.
-
Alginate (Biofilm) Ink - explore alginate solvents and understand how to adjust or use the inks
Document your recipes, the ingredients and process and if there have been changes, document your unexpected discoveries:
- Document the Process:
Write down the recipes, materials, and each step of the process you used. If there were any changes or unexpected results during the process, make sure to clearly document them.
-
The names of all materials used
-
Classification of materials by type (e.g., botanical, animal-based, mineral, etc.)
-
Organize and present your samples in a systematic way
References & Inspiration¶
Carolyn Sweeney is an artist based in Portland, Oregon. She works with natural pigments made from plants and minerals to create watercolors and crayons. Her art focuses on making and using materials she gathers herself. She also teaches workshops such as “Make Your Own Materials: Oregon Mineral Watercolors” and “Natural Pigment Crayons.” She holds a Fine Arts degree from Whitman College.
Natalie Stopka is an artist and educator based in Yonkers, New York. Her work explores natural color, plant-based dyes, and handmade pigments. She combines traditional techniques such as marbling, dye extraction, and pigment precipitation with contemporary art practices.
Lucy Irma Mayes is a London-based artist, pigment maker, and researcher. She is the founder of London Pigment, a project dedicated to creating natural and urban-sourced pigments from materials found in the city
- From Plant to Pigment
Photos by Slow Lane studio
Tools¶
Equipment
-
Digital kitchen scale
-
Syringe
-
Cooking stove or heat source
-
Mixer (electric and manual)
-
Chopsticks (for manual stirring)
-
Non-reactive pots and pans (steel)
-
Aluminum bowls
-
Measuring spoons and cups
-
Iron measuring bowl
-
Glass cups (lab-grade, various sizes)
-
pH strips for color (alkalize or acido)
-
Safety goggles
-
Clean water access
-
Plastic gloves
Materials
-
Natural dye sources (Hibiscus(dry) and Red Gabbage(fresh) )
-
Alum (potassium aluminum sulfate)
-
Soda ash (sodium carbonate)
-
Cream Tartar
-
Distilled water
-
Sodium alginate
-
Calcium chloride
-
Natural fibers: Animal-based fibers, Plant-based (vegetable) fibers, Raw fabrics
Process and workflow¶
Notes on Preparing Animal and Plant-Based Fibers for Natural Dyeing¶
Photo by Berrak Zeynep Okyar
General Preparation Steps¶
- Fibers must be measured before any treatment (based on WOF – Weight of Fiber).
- All fibers should be cleaned before mordanting or dyeing.
- Cellulose-based (plant) fibers are boiled during preparation.
- Animal fibers are gently heated but never boiled to avoid damage.
Animal Fiber Preparation¶
-
Scouring Bath Gently rinse fibers in warm water with a small amount of pH-neutral soap. Avoid sudden temperature changes; high heat can damage protein-based fibers like wool and silk.
-
Mordant Bath Soak the fibers in warm water containing:
-
10–20% Alum (WOF)
- 5–10% Cream of Tartar or Vinegar (WOF) Gently heat the bath, then turn off the heat and let fibers soak for 1 hour. Again, avoid temperature shocks.
-
Plant-Based (Cellulose) Fiber Preparation¶
-
Scouring Bath Boil fibers for 30 minutes in 4L of water with 2 tablespoons of soda ash (sodium carbonate).
-
Tannin Bath (optional) To improve mordanting: simmer fibers for 30 minutes in water with 10–15% tannin (WOF). Rinse well after removing. Common tannin-rich sources: oak gall, sumac, chestnut, quebracho, etc.
-
Mordant Bath Simmer fibers in water with 8–10% Alum (WOF). Turn off the heat and let sit for 1 hour in the bath.
-
Practical Notes & Reminders¶
-
During preparation, it’s easy to forget measurements or what has been added to the bath. Always document quantities and steps.
-
The question "Does a drop stay in the fabric or in the mixture?" refers to the concentration and uptake of dye or mordant. Some of the liquid binds to the fiber; the rest remains in the solution.
-
If you're asking "What plant is this?" but the plant isn't visible in the photo, it may be a reference to tannin sources used in the bath. Common ones include oak gall, sumac, chestnut, etc.
-
Small fabric or fiber pieces used in tests are called samples or swatches. If larger, they may be referred to as sample rolls.
-
When documenting, always take photos and label clearly:
-
Include fiber type
- Animal or plant origin (e.g. "Portuguese wool")
- Mordant and dye used This helps track how fiber source affects final color results.
Ingredients & Recipes¶
1. Red Gabbage Natural Dye¶
* 7gr gr alum
* Total 72.9 gr Animal Fiber & fabric
* 4.05 gr Cream Tartar
* 1.4 Ml Water
* 170 gr Red gabbage
Red Cabbage Ink – pH Modification Tests
Red Cabbage Natural Ink Test -Ph Modicifications by Berrak Zeynep Okyar
After extracting the red cabbage dye, we divided the liquid evenly into four 100 ml samples and applied different modifiers to observe pH-based color shifts:
Sample 1 – Acidic Modification:
100 ml red cabbage extract Added 0.5 g Sodium Alum Resulting pH: ~4–5 (acidic) Expected color: Pink to reddish tones
Sample 2– Control Group:
100 ml red cabbage extract No modification Measured pH: 6 (neutral) Expected color: Purple
Sample 3 – Light Alkaline Modification:
100 ml red cabbage extract Added 0.06 g Soda Ash Measured pH: 7.8 (slightly alkaline) Expected color: Bluish-purple
Sample 4– Strong Alkaline Modification:
100 ml red cabbage extract Added 0.20 g Soda Ash Measured pH: 11 (highly alkaline) Expected color: Green
Red Gabbage natural dye on (%100) silk fabric by Berrak Zeynep Okyar
Red Gabbage natural dye on (%100) cotton yarn by Berrak Zeynep Okyar
Red Gabbage natural dye on (%100) linen yarn by Berrak Zeynep Okyar
Red Gabbage natural dye on (%100) silk fabric by Berrak Zeynep Okyar
🧪 Red Gabbage - Alginate-Based Ink & Biofilm Production¶
Alginate painting ink by Berrak Zeynep Okyar
🔹 Objective:
To transform red cabbage dye samples (A, B, C, D) into alginate-based inks and produce biofilm with a thicker, gel-like texture suitable for painting and surface application.
Alginate painting preparations by Berrak Zeynep Okyar
-150 ml red cabbage dye (4 variations: A, B, C, D)
-
4 g Sodium Alginate
-
10 ml Glycerin
🧫 Process:
Alginate painting Samples (Red gabbage& Hibiscus Flower) by Berrak Zeynep Okyar
Each 150 ml of dyed liquid was mixed with 4 grams of sodium alginate and 10 ml of glycerin.
The mixture was stirred until fully blended, forming a gel-like, viscous ink.
This consistency allows better control over application and supports biofilm formation.
Application Tests:
Alginate Painting tests to paper and fabric by Berrak Zeynep Okyar
Each of the four ink samples (A, B, C, D) was tested on:
Natural fabric
Paper surfaces
The application revealed noticeable differences in:
Color intensity,
Texture and consistency,
Absorption levels,
Drying time
🎨 Group Overview:
Group pH Modifier pH Value Color Tone Texture After Alginate
A 0.5 g Alum ~4–5 Purple , soft gel
B None (Control) 6 violet Purple Medium gel
C 0.06 g Soda Ash 7.8 Bluish Purple Slightly thicker gel
D 0.20 g Soda Ash 11 Green Firm gel
📝 Observations:
Higher pH led to a more alkaline gel, with clearer green tones.
Lower pH produced warmer hues like light purple.
The glycerin helped maintain moisture and flexibility in the biofilm.
Sodium alginate increased viscosity, making the inks suitable for painting, screen printing, or bio-textile design.
🧪 Red Gabbage Alginate-Based Ink Biofilm & Bio-Yarn¶
Red Gabbage ALginate Biofilm Wet Version test by Berrak Zeynep Okyar
Red Gabbage ALginate Biofilm Dry Version test by Berrak Zeynep Okyar
Later, we obtained algae yarns using a calcium chloride bath.
Recycling Red Cabbage Dye into pigments¶
Ingredients:
200 gr RED CABBAGE DYE
1,4l DISTILLED WATER
ALUM (Potassium aluminium sulphate) KAl(SO4)2
xxx gr SODA ASH (Sodium Carbonate)
72,9g gr FIBERS
Preparation Steps
Prepare Mordant and Alkaline Solutions
1. Alum solution:
Mix 10g of alum with 100ml of distilled water.
Stir until fully dissolved.
2. Soda ash solution:
Mix 5g of soda ash with 100ml of distilled water.
Stir until fully dissolved.
Combine Solutions with Red Cabbage Dye
Pour the red cabbage dye into a tall jar.
Add the alum solution to the dye and mix thoroughly.
Add the soda ash solution to the dye mixture.
Stir carefully to avoid splashing.
Testing the Dye
On Paper:
Dip filter paper or watercolor paper into the dye to observe the color reaction.
On Fibers:
Submerge natural fibers (cotton, wool, silk, etc.) in the dye bath.
Leave fibers in the solution for 4 days to allow full absorption.
Storage Store the remaining dye solution in a sealed container in the refrigerator to preserve its potency.
2. Hibiscus sabdariffa L. Natural Dye¶
Materials
• Dried hibiscus flowers – 100 g
• Water – approximately 2 liters
• Fibers or fabrics to dye
• pH strips or pH meter (target: around pH 2)
• Stainless steel (inox) pot and containers
• Spoon or scoop for stirring
• Stove or heating plate
• Protective equipment (gloves, apron, etc.)
1. Preparing the Dye Bath
-
Add 100 g of dried hibiscus flowers to about 2 liters of water.
-
Bring the mixture to a boil.
-
Once boiling, reduce the heat and keep at 80 °C for 30–45 minutes.
-
Pre-wet and clean the fibers or fabrics to ensure even dye absorption.
-
Submerge the materials completely in the prepared dye bath.
-
Keep them in the bath for 30 minutes.
-
For lighter pink tones, remove the fibers after 30 minutes.
-
For darker red tones, turn off the heat and leave the fibers in the dye bath overnight.
2. pH Control and Post-Treatment
-
Measure the pH of the dye bath — it should be around pH 2.
-
Divide the dyed fibers into three equal parts.
-
Rinse and dry one part immediately to fix the color.
-
The remaining parts can be used for further tests (different times, heat, or mordants).
⸻
Hibiscus dye on Silk Fabric by Carlotta Premazzi 3. Drying and Storage
• Dry the rinsed samples in a well-ventilated, shaded area (avoid direct sunlight).
• Label each sample with its date, duration, temperature, pH, and material type for accurate documentation.
Hibiscus dye on Wool Fiber test by Carlotta Premazzi
Hibiscus dye on Linen Fabric test by Carlotta Premazzi
Hibiscus dye on Silk Fabric test by Carlotta Premazzi
4.🧪 Hibiscus Flower - Alginate-Based Ink & Biofilm Production
WILL ADD description,A PHOTO ABOUT FABRICS AND YARN, Results
Documenting experiments¶
WILL ADD A PHOTO ABOUT A FOLDER WITH FABRICS AND YARN,INK!
RESULTS¶
Biochrome Book by Berrak Zeynep Okyar